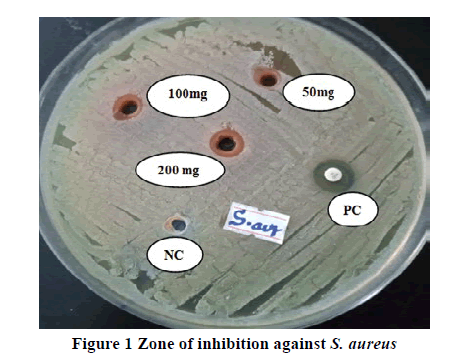
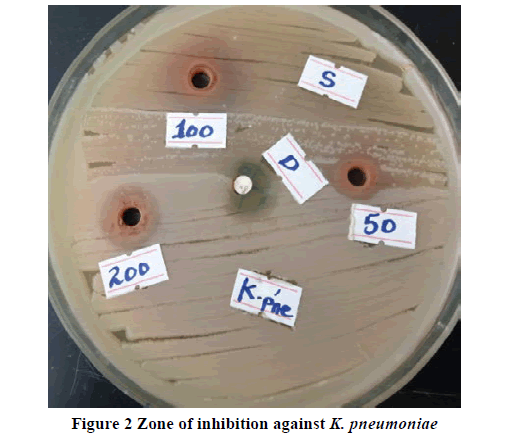

Research - International Journal of Medical Research & Health Sciences ( 2021) Volume 10, Issue 3
In-vitro Antibacterial Activity of the 80% Methanolic Leaf Extract of Maytenus gracilipes (Welw. ex Oliv) Exell. (celastraciae) against Some Pathogenic Bacteria
EslemanYessuf1, Elias Adugna1, Dejen Nureye1*, Muktar Sano Kedir1,2, Workineh Woldeselassie Hammeso1, Nebeyi Fisseha1 and TeshaleWorku32Department of Pharmacy, College of Health Sciences, Arsi University, Asella, Ethiopia
3Department of Medical Laboratory Sciences, College of Medicine and Health Sciences, Mizan- Tepi University, Aman Campus, Mizan-Aman, Southwest, Ethiopia
Dejen Nureye, Department of Pharmacology and Toxicology, School of Pharmacy, College of Medicine and Health Sciences, Mizan-Tepi University, Aman Campus, Southwest, Ethiopia, Tel: +251 47 336 0035, Email: dejenureye@gmail.com
Received: 23-Feb-2021 Accepted Date: Mar 23, 2021 ; Published: 30-Mar-2021
Abstract
Background: Challenges by drug-resistant bacteria have stimulated renewed interest in medicinal plants as a major source of new medicines. The leaf of Maytenus gracilipes has been used as ethnomedicine for the treatment of tonsillitis and ear infections in Ethiopia. However, its antimicrobial potential has not been evaluated. This study aimed to screen the antibacterial activities of M. gracilipes leaves. Methods: In this study, the antibacterial activities of crude methanolic leaf extract were tested against two Gram-positive and three Gram-negative bacteria using the agar well diffusion method at different concentrations (50 mg/ml, 100 mg/ml, and 200 mg/ml). Augmentin 0.3 mg/disc and Ciprofloxacin 0.05 mg/disc were used as a standard drug. The minimum inhibitory concentration of the crude extract was determined by the broth dilution method. A preliminary phytoconstituent analysis was also carried out. Results: The crude extract inhibited the growth of the tested bacteria in a concentration-dependent manner. Klebsiella pneumoniae and Escherichia coli were the most susceptible studied species. Promising antibacterial activities with the highest zone of inhibition (20 mm) were exhibited against K. pneumoniae at a concentration of 200 mg/ml. The highest dose of the extract was displayed zone of inhibitions against Staphylococcus aureus and K. pneumoniae without remarkable difference compared to the respective positive control. The MIC values of methanolic extract were ranged from 12.5 mg/ml to 25 mg/ml. The MBC values attained ranged from 25 mg/ml to 50 mg/ml. Conclusion: The extract showed a wide spectrum activity with better effect against Gram-negative bacteria. As such, the phytotherapeutic potential of this plant in treating bacterial infections should further be established through detailed in vitro and in vivo studies.
Keywords
Antibacterial activity, Extract, Maytenus gracilipes, Klebsiella pneumoniae, Escherichia coli
Introduction
Deaths caused by the infectious disease are common in Low-and Middle-Income Countries (LMIC). For example, the leading cause of death in Kenya is diarrheal diseases. HIV/AIDS is the leading cause of death in South Africa and Botswana [1]. Since the discovery of penicillin, antimicrobials have saved million’s life and also eased the pain and suffering of humans secondary to infectious diseases. However, after more than 75 years of indiscriminate and widespread use, many antimicrobial agents are not as effective as they used to be. Consequently, the number of deaths caused by infectious diseases is falling slowly worldwide [2].
Several studies conducted in European countries revealed that severe infections caused by Gram-negative bacteria, including those strains resistant to multiple classes of antibiotics, and are significantly increasing over the last years. Especially those third-generation cephalosporins-resistant Enterobacteriaceae, Multi-Drug Resistance (MDR) Acinetobacter baumannii and Pseudomonas aeruginosa are increasing [3]. In South Asian countries, neonatal sepsis causing organisms that are associated with antimicrobial drug resistance, such as S. aureus, E. coli, Enterobacter and Acinetobacter species, and Pseudomonas, caused estimated deaths of 300,000 infants annually [4].
According to the most recent estimates, a total of 700,000 people die every year from drug-resistant strains of common infections organisms. By 2030, Antimicrobial Resistance (AMR) could force up to 24,000,000 people into extreme poverty. If no action is taken, drug-resistant diseases could cause 10,000,000 deaths each year by 2050 [5]. Generally, insufficient research in novel drug development, with the current rising rates of AMR, irrational use of antibiotics for humans and food animals, and uncoordinated overall international technical and nontechnical efforts, could result in a time in which treatment of many infections is impossible [6]. Thus, to address the impact of AMR on medical, social, and economic burdens, real and unreserved global coordinated efforts in the development of new antibacterials have to be taken. Since medicinal plants remain the main focus of scientists and researcher globally as a novel source of principal compounds in the development of new antibiotics, it is extremely important to undergo urgent and intensive research to come up with qualified, safe, efficacious, and affordable antimicrobial agents from natural products particularly medicinal plants [7].
Ethiopia, with a wealth of unexplored natural products, is an ideal place to search for a new medicine for the treatment of infectious diseases. Even though some studies have been conducted to explore the antimicrobial potential of various medicinal plants, these studies are insufficient as compared to the current widespread problem and prevalence of drug resistance microbe as well as the urgent needs of new medicine [8]. In Ethiopia, M. gracilipes (Celastraceae) are widely distributed in different regions. It is a shrub or bushy tree up to 5 mm-10 m high [9]. Leaves of M. gracilipes are used to treat epilepsy, malaria, tumor, and tonsillitis, and ear infections [10,11]. Despite its use as traditional medicine, no antibacterial studies of M. gracilipes have been conducted to date. Therefore, this study aimed to screen the antibacterial activities of 80% methanolic extract of M. gracilipes leaves against S. aureus, S. pyogenes, P. aeruginosa, E. coli, and K. pneumoniae.
Materials and Methods
Collection of Plant Material
For this laboratory-based study, fresh leaves of M. gracilipes were collected in September 2020 from its natural habitat around Andracha woreda, Sheka zone, Southwest Ethiopia, about 576 km from Addis Ababa. The leaves were covered in a plastic bag during transportation. The collected plants were then identified and authenticated as Maytenus gracilipes (Welw. ex Oliv) Exell. by a taxonomist at the National Herbarium, College of Natural and Computational Sciences, Addis Ababa University, where voucher specimens (no. EY 001) were deposited for future reference.
Preparation of Plant Extract
The plant material was thoroughly washed with tap water and cleaned with gauze to remove dirt and soil. The sample was then air-dried under the shade and crushed into a coarse powder using sterile pestle and mortar. Subsequently, 150 g powder of M. gracilipes was extracted by cold maceration technique with 80% methanol (200 ml) solution in an Erlenmeyer flask for 3 consecutive days at room temperature. The extraction process was facilitated by occasional shaking using an orbital shaker (Bibby Scientific Limited Stone Staffo Reshire, UK) at 120 revolutions per minute. The extract was filtered using gauze and then with Whatman filters paper No. 1 (Maidstone, UK). The residue was re-macerated for the second and third times with the same volume of fresh solvent to increase the amount of the extract obtained at the end of the extraction process. The filtrates were combined and concentrated by a Rotary evaporator (Buchi Rotavapor R‑200, Flawil, Switzerland) under reduced pressure (150 mbar). All extracts were then dried and further concentrated using a dry oven (Okhia industrial area, India) with a temperature not exceeding 40°C. Finally, the extract was transferred into an amber glass bottle and kept at -20°C until required for the experiment. From 150-gram coarse powder of the plant material, a percentage yield of 18 gram (12% w/w) crude extract was obtained. The extract yield was determined using the following formula.

Preliminary Phytochemical Screening
The extract was tested using standard procedures for the presence of various phytoconstituents, namely alkaloids, anthraquinone glycosides, cardiac-glycosides, flavonoids, saponins, tannins, and terpenoids [12,13].
Test Organisms
Standard bacterial strains of two Gram-positive bacteria (S. aureus ATCC 29213 and S. pyogenes ATCC 19615) and three Gram-negative bacteria (P. aeruginosa ATCC 27853, E. coli ATCC 25922, and K. pneumoniae ATCC 700603) were obtained from Ethiopian Public Health Institute and used in this study. They were preserved at -20°C until the preparation of inoculums. The bacteria were selected based on the availability and by considering the likely bacterial strains that can cause bacterial infections for which the experimental plant is indicated traditionally. Each bacterial strain was activated by streaking on culture media aseptically. For S. aureus ATCC 29213, P. aeruginosa ATCC 27853, E. coli ATCC 25922, and K. pneumoniae ATCC 700603, nutrient agar was used, and for S. pyogenes ATCC 19615, 5% sheep blood agar was used. The culture media inoculated with S. pyogenes was enclosed in a candle jar to supply 5%-10% of carbon dioxide. All the inoculated strains were incubated for 24 h at 37°C in an incubator. Then, the inoculum of each bacterium was prepared by taking 3-5 colonies and transferring them to tubes containing 5 ml of normal saline. The immersed colonies of bacteria were mixed gently to form a homogeneous suspension until the turbidity of the suspension became attuned to 0.5 McFarland standards (1.5 × 108 CFU/ml) [14].
Antibacterial Activity Assay
The assay was conducted using the agar well diffusion method as described previously [15]. A sterile cotton swab was briefly dipped into the adjusted suspension by rotating several times and pressing firmly on the inside wall of the tube above the fluid level to remove excess inoculums from the swab. This was done to maximize the uniform distribution of test microorganisms on the medium. The suspension was streaked in three different directions by rotating at sixty degrees on sterile Mueller-Hinton Agar (MHA) plates. For S. pyogenes, MHA supplemented with sheep blood (5% v/v) was used. On each inoculated plate, five equidistant wells were made with a 6 mm diameter sterilized cork borer and labeled with numbers corresponding to the extract placed. Each well was then filled with 100 μl of 200 mg/ml, 100 mg/ml, and 50 mg/ml solutions of the crude extract. The commercial antibiotic discs, augmentin 0.3 mg/disc (for S. aureus and S. pyogenes) and ciprofloxacin 0.05 mg/disc (for P. aeruginosa, E. coli, and K. pneumoniae), were used as a positive control. Distilled water used to dissolve the crude extract was used as a negative control. The plates were then left undisturbed for about 2 h at room temperature give time to diffusion on the inoculated agar. Finally, the plates contain the inoculum was incubated at 37°C for 24 h. Antibacterial activity was interpreted by measuring the diameter of clear inhibition zones surrounding the wells. All of the tests were performed in triplicates to ensure quality and the mean values were calculated.
Determination of Minimum Inhibitory Concentration
The Minimum Inhibitory Concentration (MIC) values were determined using the broth dilution method through the two-fold serial dilution technique. The first test tubes contained the stock solution (800 mg/ml) of the crude extract for each test organism and were subjected to serial dilution with Mueller-Hinton Broth (Brain Heart Infusion for streptococcus species) with a final concentration of 200 mg/ml to 1.56 mg/ml. One ml of standardized microbial suspension was added to each test tube. The last two columns were served as positive and negative controls. The positive control (without extract) contained the broth with the respective bacterium for comparing the turbidity status. The negative control (used to test the sterility of the broth) contained the broth with extract in serial dilutions in the absence of bacterium. The test tubes were then incubated at 37°C for 24 h. The MIC was determined as the lowest concentration of the extract at which no turbidity (bacterial growth) occurred. The test was performed in triplicates to ensure quality and the mean values were calculated.
Determination of Minimum Bactericidal Concentration
The contents of the MIC test tubes containing a concentration of test material above or equal to the MIC value were sub-cultured aseptically on MHA or MHA supplemented with 5% v/v sheep blood (for Streptococcus species). The agar plates were then incubated at 37°C for 24 h. The lowest extract concentration that completely exterminates the bacterial population on agar plates was considered to be the MBC value. The test was performed in triplicates to ensure quality and the mean values were calculated.
Statistical Analysis
Data were organized, edited, and analyzed using SPSS version 22 for Windows (IBM Corp., Armonk, NY, USA). The values of the antibacterial activity were expressed as mean ± standard error of the mean. Data obtained from antibacterial activity tests were analyzed with one-way ANOVA followed by Tukey post hoc test to compare the inhibition zone against the selected bacteria between control and treatment groups. Results were considered statistically significant if p-values <0.05 at 95% confidence intervals.
Results
Preliminary Phytochemical Screening
The qualitative preliminary phytochemical screening of the 80% methanol leave extract of M. gracilipes revealed the presence of all the tested phytochemicals except anthraquinone glycoside and terpenoids (Table 1).
Table 1 Preliminary phytochemical screening of the hydroalcoholic extract of M. gracilipes leaves
| Tests | Phytoconstituents | ||||||
|---|---|---|---|---|---|---|---|
| Terpenoids | Saponins | Tannins | Flavonoids | Cardiac glycosides | Alkaloids | Anthraquinone glycoside | |
| Salkowski | − | ||||||
| Foam | + | ||||||
| Ferric chloride | + | ||||||
| Lead acetate | + | ||||||
| Keller-Kilian | + | ||||||
| Mayer’s | + | ||||||
| Bornterager | − | ||||||
+: Present; −: Absent
Screening of Antibacterial Activity
The antibacterial activities of 80% methanolic extract of M. gracilipes against each bacterium are tabulated in Table 2. The negative control, which was the vehicle used to dissolve the extract, was not able to show any detectable inhibition against all tested bacteria. All doses of the plant extract exhibited antibacterial activities against all test organisms in a dose-dependent fashion. From the doses of the plant studied, the highest concentration of the extract (200 mg/mL) was showed a statistically significant area of inhibition against S. aureus (p<0.05; Figure 1), E. coli (p<0.01), and K. pneumoniae (p<0.01) as compared to the middle concentration (100 mg/ml). Best antibacterial activities with a maximum zone of inhibition (20 mm) were recorded at 200 mg/ml against K. pneumoniae (Figure 2) followed by 17 mm growth inhibition against E. coli (Figure 3) at the same dose. The highest concentration also exhibited a significantly higher zone of inhibition against each bacterium as compared to the respective lowest concentration (50 mg/mL). Moreover, the highest dose attained an inhibitory effect against S. aureus and K. pneumoniae, with no significant differences compared to the respective positive control but greater by 1 mm against K. pneumoniae. When the middle dose of the plant material was compared with the lowest dose, a significant difference (p<0.01) was observed only against K. pneumoniae. Almost at all concentration levels, the plant extract demonstrated higher inhibition diameters against K. pneumoniae and E. coli than the remaining tested bacteria. The inhibition zones shown by all concentrations of the extract against S. pyogenes (Figure 4), P. aeruginosa (Figure 5), and E. coli were significantly lesser (p<0.01) than the respective positive control (Table 2). Additionally, the lower doses against S. aureus and the lowest dose against K. pneumoniae were displayed notably lesser (p<0.01) zone of growth inhibition than the standard drugs.
Table 2 Mean zone of inhibition (mm) of different bacteria at various concentrations of the test extract of the experimental plant against five pathogenic bacteria
| Group | Gram-positive bacteria | Gram-negative bacteria | |||
|---|---|---|---|---|---|
| S. aureus | S. pyogenes | P. aeruginosa | E. coli | K. pneumoniae | |
| NC | NAA | NAA | NAA | NAA | NAA |
| MG50 | 10.00 ± 0.58u*x*z* | 9.00 ± 0.58u*x*z* | 9.10 ± 0.26u*x**y* | 10.13 ± 0.47u*x*y* | 14.00 ± 0.17u*w* x* y* |
| MG100 | 11.33 ± 0.60u*x**z* | 11.17 ± 0.33u*z* | 11.00 ± 0.92u*y* | 12.03 ± 0.20u* x*y* | 16.93 ± 0.81u*v*x* |
| MG200 | 14.00 ± 0.58u*v*w* | 14.00 ± 1.15u*v*z* | 13.00 ± 1.15u*v*y* | 17.00 ± 1.15u*v*w* y* | 20.00 ± 0.58u*v*w* |
| PCC | NT | NT | 27.00 ± 0.58u*v*w* x* | 22.00 ± 0.58u*v*w* x* | 19.00 ± 0.58u*v* |
| PCA | 16.00 ± 0.58u*v*w* | 21.00 ± 0.58u*v*w* x* | NT | NT | NT |
Values are described as mean ± SEM (n=3). NC: Negative Control; MG: M. gracilipes; PCC: Positive Control (Ciprofloxacin 0.05 mg/disc), PCA: positive Control (Augmentin 0.3 mg/disc); NAA: No Antibacterial Activity; NT: Not Tested; SEM: Standard Error of Mean; u: compared to NC; v: compared to 50 mg/ml; w: compared to 100 mg/ml; x: compared to 200 mg/ml; y: compared to PCC; z: compared to PCA; *p<0.01; **p<0.05. In the first column, numbers next to letters (50, 100, and 200) represent dose in mg/ml
Determination of MIC and MBC Values
The extract shows MIC value ranges from 12.5 mg/ml against E. coli and K. pneumoniae to 25 mg/ml against S. pyogenes and P. aeruginosa. The MBC values were ranges from 25 mg/ml against E. coli and K. pneumoniae to 50 mg/ml against S. pyogenes and P. aeruginosa (Table 3).
Table 3 MIC and MBC (in mg/mL) of the extract against tested bacteria
| Bacteria | Crude extract | |
|---|---|---|
| MIC | MBC | |
| S. aureus | 20.8 | 41.6 |
| S. pyogenes | 25 | 50 |
| P. aeruginosa | 25 | 50 |
| E. coli | 12.5 | 25 |
| K. pneumoniae | 12.5 | 25 |
Discussion
From day to day, morbidity and mortality caused by bacterial infections are increasing partly due to the lack and high cost of new antibacterials as well as widespread resistance to old antibacterial agents. As a consequence, there is a necessity to search for effective plant origin and new antimicrobial compounds. The preliminary results of this study, therefore, indicate the potential of this study plant for developing an effective antibacterial drug in the future [16]. The organic solvent was used for extraction, as this has been reported to result in higher antibacterial effects compared with water extract and does not confer any negative outcome on the bioactivity against the bacteria tested [17,18]. Furthermore, most of the secondary metabolites of medicinal plants have aromatic rings and hence best extracted by organic solvents [19].
To the best of the authors’ knowledge, this is the first experimental study on the bioactivity and phytochemicals of M. gracilipes extract. The qualitative phytoconstituent screening has verified the presence of different secondary metabolites in the extract (Table 1), which are well known to elicit antibacterial effects through different mechanisms in other plants [20,21]. Secondary metabolites of plants have involvement in resistance against diseases. Thus, the activity of the plant in this study, at all tested concentration levels, against every tested bacterium may be associated with the existence of these chemicals that act individually or synergistically [16,22]. This assertion is further evidenced by a previous study that reports the antibacterial activity of other species of the same genus M. heterophylla [23]. The current experimental plant material may likely contain antibacterial constituents against pathogenic microbes other than those tested in this study.
In line with the previous study on hydromethanolic extract of Myrtus communis leaves, 80% methanolic extract M. gracilipes leaves showed concentration-dependent antibacterial activity against all tested bacteria [24]. An interesting effect has been recorded against both Gram-positive and Gram-negative bacterial species. This wide spectrum activity may be ascribed to the availability of new secondary metabolites in the plant. There is an expectation that the plant demonstrating a broad spectrum of activity may help to discover novel antibacterial metabolites [25]. Flavonoids, one of the phytochemicals found in the study plant, are eminent to be effective antimicrobial agents against a wide range of microbes. Indeed, flavonoids are a diverse group of secondary metabolites that frequently exist relatively in high concentrations in plants. The bioactivity is attributed to their ability to make a complex with the bacterial cell wall and with soluble and extracellular proteins [26]. Similarly, alkaloids, detected in this study, have a growth inhibition tendency against various Gram-positive and Gram-negative microorganisms [27].
Better antibacterial activities were obtained from this extract against the test microbes at a concentration of 200 mg/ml, which is concordant with the findings of Romha, et al. [28]. In terms of Gram-positive coverage, the plant material had almost similar activity profiles at the respective and comparable doses, thereby suggesting that closeness in the outer membrane features between the two bacteria (S. aureus and S. pyogenes) could be the factor as they are in the same class. E. coli and K. pneumoniae were more susceptible to the crude extract than other tested bacteria including those Gram-positive bacteria. Less susceptibility of P. aeruginosa than other tested Gram-negative microbes in this work could be attributed to the ability of this particular organism to survive in adverse environments and develop antibiotic resistance through reduction of porin channels, production of extended-spectrum b-lactamase, mutation of topoisomerase II and IV and expression of AmpC β-lactamase [29]. So, we may conclude that Gram-negative bacteria were more sensitive to the extract than Gram-positive bacteria. Despite the studied plants were different, this observation is in agreement with previous studies [30-32]. In contrary to the present finding, a large number of studies asserted that extracts from many medicinal plants exhibited better activities against Gram-positive bacteria than Gram-negative bacteria [19,28,33]. These dissimilarities inactivity could be associated with (a) previous encounters of the bacteria with the active ingredients of the plant material or (b) nature of the medium used [32]. On the other hand, the outer membrane may not be a major barrier to antibacterial effects for this crude extract, which is further supported by the comparable activity among the Gram-positive microorganisms (S. aureus and S. pyogenes) and Gram-negative organism (P. aeruginosa).
Except at the higher dose against S. aureus and both the middle and lower dose against K. pneumoniae, the active components of M. gracilipes did not produce a significant biological activity as compared to the standard agents. This limited potency might be occurred due to the crude nature of the plant extract [33]. Overall, the antimicrobial activity of the current extract could be contributed by its active metabolites including saponins, glycosides, and tannins [19]. Saponins may follow mode of actions similar to flavonoids (mentioned above). The mechanism of actions used by tannins may be linked to their ability to inactivate microbial adhesion, cell envelope transport proteins, and several enzymes [34].
Determination of MIC values was done to assess the effectiveness of the extract whether it inhibits the growth of the tested bacteria or not. In the current study, the MIC values of the extract were agreed with its corresponding zone of inhibitions. The results found were in consonance to the assertion that the plant extract with high bioactivity against a particular microbe usually gives low MIC and vice versa [34]. The MIC values obtained in this study were lower than the respective MBC values showing that the plant extract was bacteriostatic at lower concentration but bactericidal at higher concentration [35]. However, the extract revealed the same MIC and MBC values (in mg/mL) against E. coli and K. pneumonia, but a lower mean zone of inhibition (mm) against E. coli than K. pneumonia. The difference in inhibition zone among these two bacteria could be contributed by (a) difference in the technique used [the extract needs to diffuse in MHA plates to get a zone of inhibition (disk diffusion method) while directly added or mixed with a bacteria in MIC and MBC tests (broth dilution method)], (b) only three concentrations are used to get a zone of inhibition but more than 3 concentrations through serial dilution are used to test MIC and MBC, or (c) E. coli may be somehow resistant against the active components of the extract than K. pneumonia.
Although the in vitro activity of this study demonstrates that the extract from M. gracilipes leaves is effective against the tested bacterial species, we are not sure about the occurrence of this activity in vivo studies [22,33]. Hence, further in vitro studies on solvent fractions against tested and additional bacterial species as well as in vivo investigation of this medicinal plant should be carried out in the future.
Conclusion
The hydromethanolic crude extract of Maytenus gracilipes leaf has in vitro anti-bacterial activities. The highest concentration level of the extract showed a better antibacterial effect. The present study revealed that the extract has a broad spectrum of antibacterial activity against the tested bacteria with better efficacy against Gram-negative bacteria. Hence, this study provides evidence that supports the ethnomedical uses of the plant to treat bacterial infections. The further detailed investigation aimed at explanation of the mechanism of action, fractionation, and isolation of active substances from the extract should be done in future to develop novel antibiotics.
Declarations
Acknowledgments
We thank the Head of Medical Biochemistry Lab along with all Lab staff who aid us in the practical part of the research.
Conflicts of Interest
The authors declared no potential conflicts of interest with respect to the research, authorship, and/or publication of this article.
References
- Ritchie, Hannah, and Max Roser. "Causes of death." Our World in Data, 2018.
- ECDC, EMEA. "The bacterial challenge-time to react a call to narrow the gap between multidrug-resistant bacteria in the EU and development of new antibacterial agents." Solna: ECDC and EMEA Joint Press Release, 2009.
- De Angelis, Giulia, et al. "Burden of antibiotic resistant gram negative bacterial infections: Evidence and limits." Journal of Medical Microbiology and Diagnosis, Vol. 3, No. 1, 2014, p. 1.
- Van der Velden, Alike, et al. "Prescriber and patient responsibilities in treatment of acute respiratory tract infections-essential for conservation of antibiotics." Antibiotics, Vol. 2, No. 2, 2013, pp. 316-27.
- World Health Organization. "New report calls for urgent action to avert antimicrobial resistance crisis." World Health Organization website. https://www. who. int/news-room/detail/29-04-2019-new-report-calls-for-urgent-action to avert-antimicrobial-resistance-crisis. Accessed April 4, 2020.
- Spellberg, Brad, et al. "The epidemic of antibiotic-resistant infections: A call to action for the medical community from the Infectious Diseases Society of America." Clinical Infectious Diseases, Vol. 46, No. 2, 2008, pp. 155-64.
- Beyene, Belay, Belachew Beyene, and Habitamu Deribe. "Review on application and management of medicinal plants for the livelihood of the local community." Journal of Resources Development and Management, Vol. 22, No. 1, 2016, pp. 33-39.
- Chekesa, Basha, and Yelamtsehay Mekonnen. "Antibacterial activity of Moringa stenopetala against some human pathogenic bacterial strains." Science, Technology and Arts Research Journal, Vol. 4, No. 2, 2015, pp. 190-98.
- Yineger, Haile, et al. "Ethnoveterinary medicinal plants at bale mountains national park, Ethiopia." Journal of Ethnopharmacology, Vol. 112, No. 1, 2007, pp. 55-70.
- Abebe, Dagne, and Belachew Garedew. "Ethnobotanical survey of plants traditionally used for malaria prevention and treatment in indigenous villages of Tepi Town South West Ethiopia." Journal of Pharmacognosy and Phytotherapy, Vol. 11, No. 1, 2019, pp. 9-16.
- Kassa, Zewdie, Zemede Asfaw, and Sebsebe Demissew. "Ethno-ecological study of medicinal and wild edible plants in Sheka Zone, Southern Nations, Nationalities and Peoples Regional State, Ethiopia." Journal of the Society for Tropical Plant Research, Vol. 7, No. 1, 2020, pp. 65-75.
- Ayoola, G. A., et al. "Phytochemical screening and antioxidant activities of some selected medicinal plants used for malaria therapy in Southwestern Nigeria." Tropical Journal of Pharmaceutical Research, Vol. 7, No. 3, 2008, pp. 1019-24.
- Aiyelaagbe, O. O., and Paul M. Osamudiamen. "Phytochemical screening for active compounds in Mangifera indica leaves from Ibadan, Oyo State." Plant Sciences Research Ibadan, Vol. 2, No. 1, 2009, pp. 11-13.
- The Clinical and Laboratory Standards Institute. "Methods for dilution antimicrobial susceptibility tests for bacteria that grow aerobically; approved standard. 9th ed. M07‑A10 document." The Clinical and Laboratory Standards Institute, 2012.
- The Clinical and Laboratory Standards Institute, "Methods for dilution antimicrobial susceptibility tests for bacteria that grow aerobically; approved standard. 10th ed. M07‑A10 document" 2015.
- Akanmu, Ayodele Oluwasoji, et al. "Antibacterial activities of aqueous and methanol leaf extracts of Solanum incanum linn.(Solanaceae) against multi-drug resistant bacterial isolates." African Journal of Microbiology Research, Vol. 13, No. 4, 2019, pp. 70-76.
- Parekh, Jigna, Darshana Jadeja, and Sumitra Chanda. "Efficacy of aqueous and methanol extracts of some medicinal plants for potential antibacterial activity." Turkish Journal of Biology, Vol. 29, No. 4, 2006, pp. 203-10.
- Goyal, Pankaj, Abhishek Chauhan, and P. Kaushik. "Laboratory evaluation of crude extracts of Cinnamomum tamala for potential antibacterial activity." Electronic Journal of Biology, Vol. 5, No. 4, 2009, pp. 75-79.
- Molla, Yalew, et al. "Evaluation of the in vitro antibacterial activity of the solvent fractions of the leaves of Rhamnus prinoides L’Herit (Rhamnaceae) against pathogenic bacteria." BMC Complementary and Alternative Medicine, Vol. 16, No. 1, 2016, pp. 1-9.
- Saxena, Mamta, et al. "Phytochemistry of medicinal plants." Journal of Pharmacognosy and Phytochemistry, Vol. 1, No. 6, 2013, pp.168-82.
- Gupta, K. K., et al. "A review on scientific technologies in practice to innovate plant based molecules and to improve herbal drug quality to overcome health problems." Journal of Applied and Natural Science, Vol. 2, No. 1, 2010, pp. 165-81.
- Engiso, Hizkel, et al. "Antibacterial activity of Ritchiea albersii Gilg and Cynoglossum amplifolium leaves extracts against selected bacteria." Saudi Journal of Medicine and Medical Sciences, Vol. 8, No. 3, 2020, pp. 201-07.
- Orabi, Khaled Y., et al. "Dihydroagarofuran alkaloid and triterpenes from Maytenus heterophylla and Maytenus arbutifolia." Phytochemistry, Vol. 58, No. 3, 2001, pp. 475-80.
- Sisay, Mekonnen, et al. "Investigating in vitro antibacterial activities of medicinal plants having folkloric repute in Ethiopian traditional medicine." Journal of Evidence-Based Integrative Medicine, Vol. 24, 2019, p. 2515690X19886276.
- Sharma, B. C. "In vitro antibacterial activity of certain folk medicinal plants from Darjeeling Himalayas used to treat microbial infections." Journal of Pharmacognosy and Phytochemistry, Vol. 2, No. 4, 2013, pp. 1-4.
- Ruban, P., and K. Gajalakshmi. "In vitro antibacterial activity of Hibiscus rosa-sinensis flower extract against human pathogens." Asian Pacific Journal of Tropical Biomedicine, Vol. 2, No. 5, 2012, pp. 399-403.
- Khameneh, Bahman, et al. "Review on plant antimicrobials: A mechanistic viewpoint." Antimicrobial Resistance and Infection Control, Vol. 8, No. 1, 2019, pp. 1-28.
- Romha, Gebremedhin, et al. "Antibacterial activities of five medicinal plants in Ethiopia against some human and animal pathogens." Evidence-Based Complementary and Alternative Medicine, Vol. 2018, 2018.
- Ulloa-Urizar, Gabriela, et al. "Antibacterial activity of five Peruvian medicinal plants against Pseudomonas aeruginosa." Asian Pacific Journal of Tropical Biomedicine, Vol. 5, No. 11, 2015, pp. 928-31.
- Adamu, Mathew, Vinny Naidoo, and Jacobus N. Eloff. "The antibacterial activity, antioxidant activity and selectivity index of leaf extracts of thirteen South African tree species used in ethnoveterinary medicine to treat helminth infections." BMC Veterinary Research, Vol. 10, No. 1, 2014, pp. 1-7.
- Elisha, Ishaku Leo, et al. "The antibacterial activity of extracts of nine plant species with good activity against Escherichia coli against five other bacteria and cytotoxicity of extracts." BMC Complementary and Alternative Medicine, Vol. 17, No. 1, 2017, pp. 1-10.
- Doughari, J. H., A. M. Elmahmood, and S. Manzara. "Studies on the antibacterial activity of root extracts of Carica papaya L." African Journal of Microbiology Research, Vol. 1, No. 3, 2007, pp. 037-041.
- Marasini, Bishnu P., et al. "Evaluation of antibacterial activity of some traditionally used medicinal plants against human pathogenic bacteria." BioMed Research International, Vol. 2015, 2015.
- Mummed, Bahar, et al. "In vitro antibacterial activity of selected medicinal plants in the traditional treatment of skin and wound infections in eastern Ethiopia." BioMed Research International, Vol. 2018, 2018.
- Sen, Antara, and Amla Batra. "Evaluation of antimicrobial activity of different solvent extracts of medicinal plant: Melia azedarach L." International Journal of Current Pharmaceutical Research, Vol. 4, No. 2, 2012, pp. 67-73.